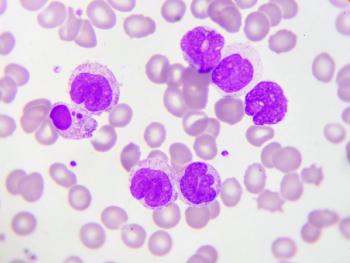

Individuals who have recovered from the initial disease are in generally poorer health later on compared with the general population, the analysis shows.
Ashley Gallagher is an editor at Pharmacy Times®. She graduated from St. Bonaventure University in 2020 in journalism and mass communications. Previously, she worked as a pharmacy technician for a retail chain.

Individuals who have recovered from the initial disease are in generally poorer health later on compared with the general population, the analysis shows.

Investigators analyzed data from nearly 4000 individuals from the National Longitudinal Study of Adolescent to Adult Health.

The findings suggest that the broad use of race as a factor for providing certain health interventions and treatments should be reconsidered, investigators say.

Scientific abstracts also address findings on cardiovascular disease and population, the connection between COVID-19 and HF, and links between prognosis and marital status.

The advisory, published in Circulation, is a call to action for a cultural shift to identify and remove barriers.

Larger increases were typically seen in states with fewer deaths related to COVID-19, lower unemployment among women, analysis finds.

Long-term extension trial results show a consistent safety profile and durable efficacy for the treatment of adults with the skin condition.

A significantly greater proportion or patients treated with either 15 or 30 mg show remission or endoscopic response or remission at week 52 compared with the placebo.

The SKYSCRAPER-01 trial evaluating the drug plus Tecentriq demonstrates that it did not meet its co-primary endpoint of progression-free survival.

The results of a network analyses show that the elevated potential of contracting the virus is also linked to infliximab and tofacitinib, as well as several combination treatments.

Analysis also indicates that individuals with the highest-level beta-cryptoxanthin in their blood were less likely to develop cognitive issues decades later.

The recommendations apply to individuals who are already taking the maximum dose of statins.

Investigators develop a genetic-risk score to identify those who would benefit most from lifestyle counseling to prevent the condition.

Second analysis indicates that parents of children with food allergies became less anxious during the pandemic.

Students in the ISU/UAA pharmacy program discuss the impact of Alaska’s first pharmacy program and what it means to learn about and work in rural communities.

Analysis shows that half of individuals with both these sensory losses are cognitively impaired, investigators say.

Results from the DELIVER and DAPA-HF phase 3 trials demonstrate AstraZeneca’s Farxiga’s efficacy in heart failure, regardless of ejection fraction.
An international phase 1/2 clinical trial is ongoing for the treatment for individuals with relapsed or refectory acute myeloid leukemia with FLT3 mutation.

First phase 3 trial in this setting shows improved overall survival rates with an immunotherapy added to chemotherapy over the standard-of-care chemotherapy alone, company says.

Individuals who are not vaccinated with pre-existing diabetes, heart artery disease, or high blood pressure had a 2- to 3-fold increased risk of death, investigators say.

Spending 1 hour less sitting a day and increasing light physical activity helps prevent diseases, investigators find.

Individuals with college debt have a higher risk of cardiovascular illness, undermining the typical benefits of a post-secondary education, data indicate.

Statistics indicate possible benefit of home-based palliative care interventions, according to study results from the Indiana University School of Medicine and the Regenstrief Institute.

Findings show that key factors include age, infecting variant, underlying illnesses, and vaccination status.

Palbociclib is indicated for adults in combination with an aromatase inhibitor as initial endocrine-based therapy in postmenopausal women or in men.

The drug combination achieved a median overall survival of more than 5 1/2 years in the first-line setting for postmenopausal women with HR+/HER2- aBC1, the company says.

Analysis results show taking iscosapent ethyl reduces the potential for CV death, coronary revascularization, hospitalization for unstable angina, myocardial infarction, and stroke by 35%.

The companies expect to complete the submission to the FDA for MDD in the first half of 2022 and an associated filing for postpartum depression in 2023.

Investigators find that 1 45-minute session of moderate intensity exercise allows more exosomes to deliver the protein, ATP7A, directly to endothelial cells, which can help enable angiogenesis.

This combination improves patient outcomes of vaccine-induced thrombotic thrombocytopenia after a COVID-19 vaccination, according to the results of a case analysis.